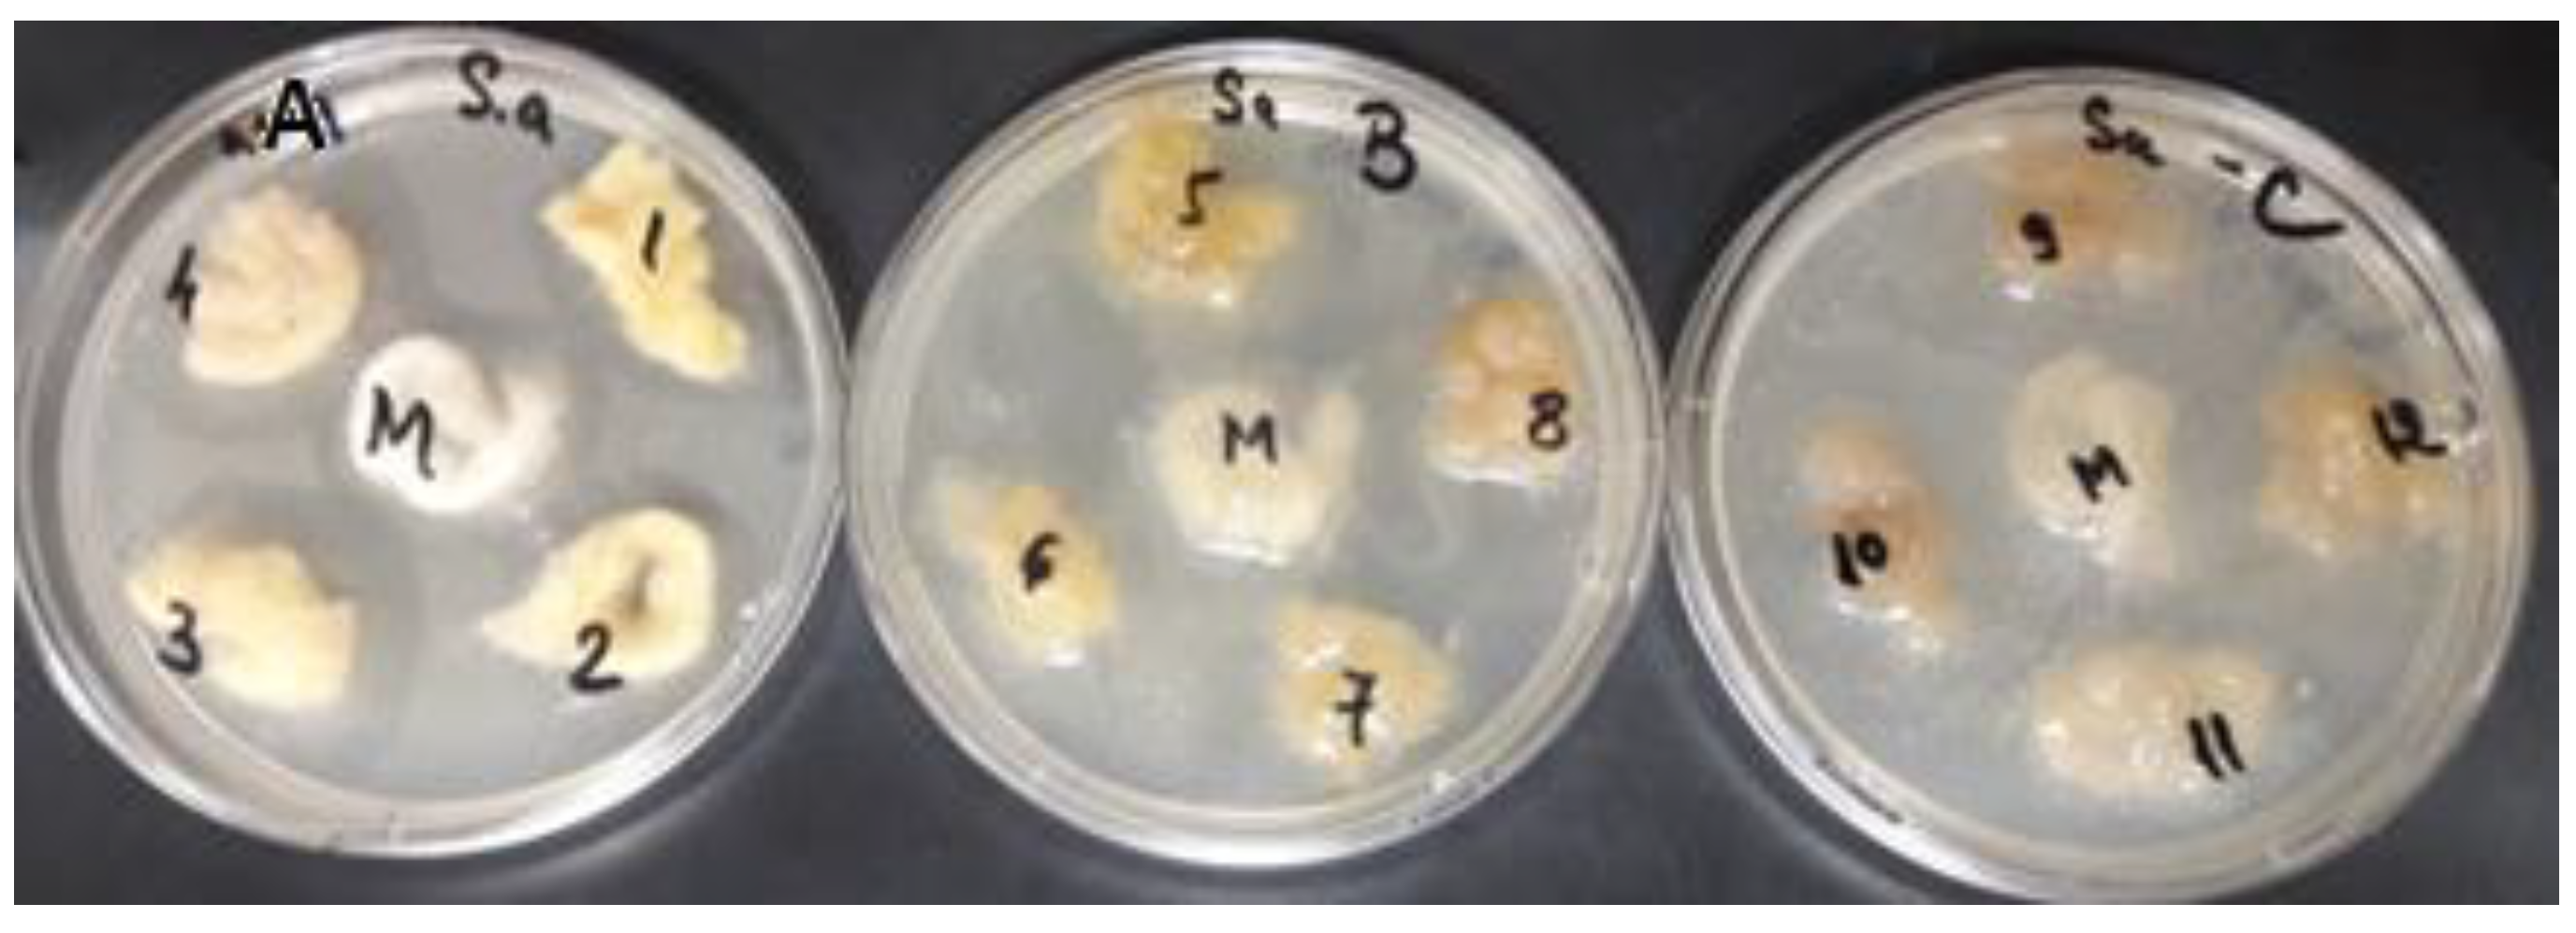
Polymers 14 03194 g015

A Sustainable Approach to a Cleaner Production of Antimicrobial and Biocompatible Protein Fibers
Abstract
:1. Introduction
2. Materials and Methods
2.1. Material
2.2. Extraction of Natural Dyes
2.2.1. Aqueous Extraction
Aqueous Method
Acidic Method
2.2.2. Alcoholic Method
2.2.3. Ultrasound Extraction
2.3. pH Measurement of Celandine Extracts
2.4. Total Polyphenol Content
2.5. Berberine Content
2.6. Dyeing
2.7. Scanning Electron Microscopy (SEM)
2.8. Determination of Levelness Index
2.9. Color Measurements
2.10. Contact Angle and Indirect Biocompatibility Studies
2.11. Antimicrobial Analysis
3. Results and Discussion
3.1. Analysis of Plant Extracts Obtained
3.2. pH Values
3.3. Total Polyphenol Content
3.4. Berberine Content
3.5. Dyeing Mechanism
3.6. Scanning Electron Microscopy
3.7. Color Measurements
3.8. Determination of Levelness Index
3.9. Contact Angle and Indirect Biocompatibility
3.10. Antimicrobial Analysis
4. Conclusions
Author Contributions
Funding
Institutional Review Board Statement
Informed Consent Statement
Conflicts of Interest
References
- Rahman, S.S.; Siddiqua, S.; Cherian, C. Sustainable applications of textile waste fiber in the construction and geotechnical industries: A retrospect. Clean. Eng. Technol. 2022, 6, 100420. [Google Scholar] [CrossRef]
- Nguyen, H.L.; Bechtold, T. Thermal stability of natural dye lakes from Canadian Goldenrod and onion peel as sustainable pigments. J. Clean. Prod. 2021, 315, 128195. [Google Scholar] [CrossRef]
- Ciric, A.; Vinterhalter, B.; Savikin-Fodulovic, K.; Sokovic, M.; Vinterhalter, D. Chemical analysis and antimicrobial activity of methanol extracts of celandine (Chelidonium majus L.) plants growing in nature and cultured in vitro. Arch. Biol. Sci. 2008, 60, 7–8. [Google Scholar] [CrossRef]
- Zielińska, S.; Jezierska-Domaradzka, A.; Wójciak-Kosior, M.; Sowa, I.; Junka, A.; Matkowski, A.M. Greater Celandine’s Ups and Downs−21 Centuries of Medicinal Uses of Chelidonium majus From the Viewpoint of Today’s Pharmacology. Front. Pharmacol. 2018, 9, 299. [Google Scholar] [CrossRef] [Green Version]
- Available online: https://www.ema.europa.eu/en/documents/herbal-report/final-assessment-report-chelidonium-majus-l-herba_en.pdf (accessed on 4 April 2022).
- Maji, A.K.; Banerji, P. Chelidonium majus L. (Greater celandine)—A Review on its Phytochemical and Therapeutic Perspectives. Int. J. Herb. Med. 2015, 3, 10–27. [Google Scholar] [CrossRef]
- Krizhanovska, V.; Sile, I.; Kronberga, A.; Nakurte, I.; Mezaka, I.; Dambrova, M.; Pugovics, O.; Grinberga, S. The Cultivation of Chelidonium majus L. Increased the Total Alkaloid Content and Cytotoxic Activity Compared with Those of Wild-Grown Plants. Plants 2021, 10, 1971. [Google Scholar] [CrossRef]
- Kopyt’Ko, Y.F.; Dargaeva, T.D.; Sokol’Skaya, T.A.; Grodnitskaya, E.I.; Kopnin, A.A. New methods for the quality control of a homeopathic matrix tincture of greater celandine. Pharm. Chem. J. 2005, 39, 603–609. [Google Scholar] [CrossRef]
- Awuchi, C.G. The Biochemistry, Toxicology, and Uses of the Pharmacologically Active Phytochemicals: Alkaloids, Terpenes, Polyphenols, and Glycosides. J. Food Pharm. Sci. 2019, 7, 131–150. [Google Scholar] [CrossRef]
- Available online: https://www.sibran.ru/upload/iblock/2ca/2ca002ebbc92ce2c30712ad444998935.pdf (accessed on 4 April 2022).
- Gaba, S.; Saini, A.; Singh, G.; Monga, V. An insight into the medicinal attributes of berberine derivatives: A review. Bioorganic Med. Chem. 2021, 38, 116143. [Google Scholar] [CrossRef]
- Golikov, V.P. Organic Chromatic Materials Based on Natural Dyes in Works of Art: Nature, Preparation and Application Technologies, Research Methods; D.S. Likhachev Russian Research Institute of Cultural and Natural Heritage: Moscow, Russia, 2020; ISBN 978-5-86443-326-3. [Google Scholar]
- Kim, T.-K.; Yoon, S.-H.; Son, Y.-A. Effect of reactive anionic agent on dyeing of cellulosic fibers with a Berberine colorant. Dye. Pigment. 2004, 60, 121–127. [Google Scholar] [CrossRef]
- Haji, A. Functional Dyeing of Wool with Natural Dye Extracted from Berberis vulgaris Wood and Rumex Hymenosepolus Root as Biomordant. Iran. J. Chem. Chem. Eng.-Int. Engl. Ed. 2010, 29, 55–60. [Google Scholar]
- Kamel, M.M.; Mashaly, H.M. Coloration of Fibrin Fabric with Berberine Natural Dye with Ultrasonic Technique Using ZnO Nano Powder as Light Fastness Improving. World Appl. Sci. J. 2013, 26, 994–1001. [Google Scholar]
- Aryal, S.; Baniya, M.K.; Danekhu, K.; Kunwar, P.; Gurung, R.; Koirala, N. Total Phenolic Content, Flavonoid Content and Antioxidant Potential of Wild Vegetables from Western Nepal. Plants 2019, 8, 96. [Google Scholar] [CrossRef] [PubMed] [Green Version]
- Farid, M.; Hanaa, F.; Sherein, A. Chemical Characterization of ChelidoniumMajus Flowers with Hepatoroxicity Protective Study in Male Albino Rats. J. Vet. Sci. 2019, 8, 218–223. [Google Scholar]
- Joshi, H.; Kanak, N. Quantitative analysis of berberine in an Ayuverdic Formulation—RasayanaChurna by UV Spectrophotometry. J. Pharm. Sci. Biosci. Res. 2013, 3, 32–34. [Google Scholar]
- Andoh, T.; Yoshihisa, Y.; Rehman, M.U.; Tabuchi, Y.; Shimizu, T. Berberine induces anti-atopic dermatitis effects through the downregulation of cutaneous EIF3F and MALT1 in NC/Nga mice with atopy-like dermatitis. Biochem. Pharmacol. 2021, 185, 114439. [Google Scholar] [CrossRef]
- Suri, A.; Pratt, A.; Tear, S.; Walker, C.; El-Gomati, M. Next generation secondary electron detector with energy analysis capability for SEM. J. Microsc. 2020, 279, 207–211. [Google Scholar] [CrossRef] [Green Version]
- Mongkholrattanasit, R.; Nakpathom, M.; Vuthiganond, N. Eco-dyeing with biocolorant from spent coffee ground on low molecular weight chitosan crosslinked cotton. Sustain. Chem. Pharm. 2021, 20, 100389. [Google Scholar] [CrossRef]
- Tang, A.Y.L.; Lee, C.H.; Wang, Y.M.; Kan, C.W. Effect of Hydrophilic-lipophilic Balance (HLB) Values of PEG-based Non-ionic Surfactant on Reverse Micellar Dyeing of Cotton Fibre with Reactive Dyes in Non-aqueous Medium. Fibers Polym. 2018, 19, 894–904. [Google Scholar] [CrossRef]
- Le, C.; Ly, N.; Stevens, M. Measuring the Contact Angles of Liquid Droplets on Wool Fibers and Determining Surface Energy Components. Text. Res. J. 1996, 66, 389–397. [Google Scholar] [CrossRef]
- Barani, H.; Montazer, M.; Calvimontes, A.; Dutschk, V. Surface roughness and wettability of wool fabrics loaded with silver nanoparticles: Influence of synthesis and application methods. Text. Res. J. 2013, 83, 1310–1318. [Google Scholar] [CrossRef]
- Elmaaty, T.A.; Raouf, S.; Sayed-Ahmed, K.; Plutino, M.R. Multifunctional Dyeing of Wool Fabrics Using Selenium Nanoparticles. Polymers 2022, 14, 191. [Google Scholar] [CrossRef] [PubMed]
- Arora, J.; Agarwal, P.; Gupta, G. Rainbow of Natural Dyes on Textiles Using Plants Extracts: Sustainable and Eco-Friendly Processes. Green Sustain. Chem. 2017, 7, 35–47. [Google Scholar] [CrossRef] [Green Version]
- Available online: https://downloads.hindawi.com/journals/jfq/2019/8178294.pdf (accessed on 22 March 2022).
- Available online: https://www.ncbi.nlm.nih.gov/pmc/articles/PMC7139493/pdf/antioxidants-09-00265.pdf (accessed on 22 March 2022).
- Lin, Y.-C.; Lin, Z.-R.; Tsai, L.-W.; Perevedentseva, E.; Karmenyan, A.; Cheng, C.-L. Spectral Analysis of Nanodiamond-Berberine Complex Interaction with Living Cells for Nanoparticle Mediated Drug Delivery. J. Biomed. Photon Eng. 2017, 3, 010305. [Google Scholar] [CrossRef] [Green Version]
- Anburaj, R.; Jothiprakasam, V. Bioassay of tannin rich fraction and identification of compounds using UV-Vis, FTIR and RP-HPLC, Research Journal of Pharmaceutical. Biol. Chem. Sci. 2017, 8, 432–445. [Google Scholar]
- Mazanko, M.; Prazdnova, E.; Rudoy, D.; Ermakov, A.; Olshevskaya, A.; Maltseva, T. Extracts of medical plants suppress the SOS response and reduce mutagenesis in E. coli. E3S Web Conf. 2020, 175, 01010. [Google Scholar] [CrossRef]
- Artamonova, E.S.; Kurkin, V.A. Developing methods for qualitative and quantitative analysis of Chelidonium majus herbs. Pharm. Chem. J. 2008, 42, 633–636. [Google Scholar] [CrossRef]
- Bunghez, F.; Socaciu, C.; Zagrean, F.; Pop, R.M.; Ranga, F.; Romanciuc, F. Characterisation of an Aromatic Plant-based Formula using UV-Vis Spectroscopy, LC–ESI(+)QTOF-MS and HPLC-DAD Analysis. Bull. Univ. Agric. Sci. Veter-Med. Cluj-Napoca. Food Sci. Technol. 2013, 70, 16–24. [Google Scholar] [CrossRef] [Green Version]
- Available online: https://link.springer.com/content/pdf/10.1007/s10668-020-01017-0.pdf (accessed on 8 April 2022).
- Neag, M.A.; Mocan, A.; Echeverría, J.; Pop, R.M.; Bocsan, C.I.; Crişan, G.; Buzoianu, A.D. Berberine: Botanical Occurrence, Traditional Uses, Extraction Methods, and Relevance in Cardiovascular, Metabolic, Hepatic, and Renal Disorders. Front. Pharmacol. 2018, 9, 557. [Google Scholar] [CrossRef] [Green Version]
- Available online: https://www.google.com/url?sa=t&rct=j&q=&esrc=s&source=web&cd=&ved=2ahUKEwiO3pSooar5AhUC4GEKHWeDD2wQFnoECAIQAQ&url=http%3A%2F%2Fheritage-institute.ru%2Fwp-content%2Fuploads%2F2020%2F08%2Fgolikov-vp_organicheskie-hromaticheskie-materialy.pdf&usg=AOvVaw0l2ii0TtvmejGaJIU-PFKL (accessed on 12 April 2022).
- Available online: http://heritage-institute.ru/wp-content/uploads/2020/08/golikov-vp_organicheskie-hromaticheskie-materialy.pdf (accessed on 13 April 2022).
- Atav, R. The Use of New Technologies in Dyeing of Proteinous Fibers, from the edited volume. In Eco-Friendly Textile Dyeing and Finishing; Günay, M., Ed.; IntechOpen: London, UK, 2013; ISBN 978-953-51-0892-4. [Google Scholar] [CrossRef] [Green Version]
- Parveen, S.; Rana, S.; Goswami, P. Developing Super-Hydrophobic and Abrasion-Resistant Wool Fabrics Using Low-Pressure Hexafluoroethane Plasma Treatment. Materials 2021, 14, 3228. [Google Scholar] [CrossRef]
- Palencia, M. Surface free energy of solids by contact angle measurements. J. Sci. Technol. Appl. 2017, 2, 84–93. [Google Scholar] [CrossRef]
- Available online: https://www.biolinscientific.com/blog/what-is-surface-free-energy (accessed on 19 April 2022).
- Zhou, L.Y.; Li, Y.; Chung, J.; Tokura, H.; Gohel, M.D.I.; Kwok, Y.L.; Feng, X.W. Effects of fabric surface energy on human thermophysiological responses during exercise and recovery. Fibers Polym. 2007, 8, 319–325. [Google Scholar] [CrossRef]
- Menzies, K.L.; Jones, L. The Impact of Contact Angle on the Biocompatibility of Biomaterials. Optom. Vis. Sci. 2010, 87, 387–399. [Google Scholar] [CrossRef] [PubMed]
- Wei, D.; Xiao, W.; Sun, J.; Zhong, M.; Guo, L.; Fan, H.; Zhang, X. A biocompatible hydrogel with improved stiffness and hydrophilicity for modular tissue engineering assembly. J. Mater. Chem. B 2015, 3, 2753–2763. [Google Scholar] [CrossRef]
- Gheorghiu, M.; Popa, G.; Mungiu, O. Improving Blood and Tissue Compatibility of Poly(Ethylene Terephthalate) by Ion Beam Treatment. J. Bioact. Compat. Polym. 1991, 6, 164–177. [Google Scholar] [CrossRef]
- Buyukakinci, Y.B.; Karadag, R.; Guzel, E.T. Organic cotton fabric dyed with dyer’s oak and barberry dye by microwave irradiation and conventional methods. Ind. Text. 2021, 72, 30–38. [Google Scholar] [CrossRef]
- Haji, A.; Shoushtari, A.M. Natural antibacterial finishing of wool fiber using plasma technology. Ind. Text. 2011, 62, 244–247. [Google Scholar]
- Turhan, V.; Mutluoglu, M.; Acar, A.; Hatipoglu, M.; Onem, Y.; Uzun, G.; Ay, H.; Oncul, O.; Gorenek, L. Increasing incidence of Gram-negative organisms in bacterial agents isolated from diabetic foot ulcers. J. Infect. Dev. Ctries. 2013, 7, 707–712. [Google Scholar] [CrossRef] [Green Version]
- Burel, C.; Kala, A.; Purevdorj-Gage, L. Impact of pH on citric acid antimicrobial activity against Gram-negative bacteria. Lett. Appl. Microbiol. 2021, 72, 332–340. [Google Scholar] [CrossRef]
- Mani-López, E.; García, H.; López-Malo, A. Organic acids as antimicrobials to control Salmonella in meat and poultry products. Food Res. Int. 2012, 45, 713–721. [Google Scholar] [CrossRef]
- Móricz, M.; Fornal, E.; Jesionek, W.; Majer-Dziedzic, B.; Choma, I. Effect-Directed Isolation and Identification of Antibacterial Chelidonium majus L. Alkaloids. Chromatographia 2015, 78, 707–716. [Google Scholar] [CrossRef]
- Mohsin, M.; Farooq, U.; Raza, Z.A.; Ahsan, M.; Afzal, A.; Nazir, A. Performance enhancement of wool fabric with environmentally-friendly bio-cross-linker. J. Clean. Prod. 2014, 68, 130–134. [Google Scholar] [CrossRef]

| RUI | Visual Appearance of Levelness |
|---|---|
| <0.2 | Excellent |
| 0.2–0.49 | Good |
| 0.5–1.0 | Poor |
| >1.0 | Bad |
| Alcoholic Extract | Acidic Extract | Aqueous Extract | Ultrasound Extract | |
|---|---|---|---|---|
| pH | 7.37 | 4.26 | 7.03 | 7.05 |
| L* | a* | b* | C* | h | Sample Shade | ||
|---|---|---|---|---|---|---|---|
| Untreated wool | Aqueous extract (P1) | 66.98 | 4.79 | 40.81 | 41.09 | 83.31 |  |
| Ultrasound extraction (P2) | 67.62 | 4.09 | 22.31 | 22.68 | 79.61 |  | |
| Alcoholic extraction (P3) | 69.10 | 3.99 | 25.56 | 25.87 | 81.14 |  | |
| Acidic extraction (P4) | 66.36 | 5.07 | 26.24 | 26.72 | 79.07 |  | |
| UV activated wool | Aqueous extract (P5) | 67.68 | 4.91 | 43.13 | 43.41 | 83.51 |  |
| Ultrasound extraction (P6) | 77.02 | 1.68 | 31.59 | 31.64 | 86.96 |  | |
| Alcoholic extraction (P7) | 63.35 | 2.55 | 30.21 | 30.32 | 85.18 |  | |
| Acidic extraction (P8) | 62.79 | 3.97 | 22.79 | 23.13 | 80.11 |  | |
| wool + CA | Aqueous extract (P9) | 62.20 | 5.28 | 28.56 | 29.04 | 79.52 |  |
| Ultrasound extraction (P10) | 74.06 | 3.12 | 37.12 | 37.25 | 85.20 |  | |
| Alcoholic extraction (P11) | 65.23 | 4.39 | 35.29 | 35.56 | 82.91 |  | |
| Acidic extraction (P12) | 63.42 | 5.01 | 27.21 | 27.67 | 79.57 |  |
| Acidic Extraction | Alcoholic Extraction | Ultrasound Extraction | Aqueous Extraction | |||||
|---|---|---|---|---|---|---|---|---|
| Wool + CA | 0.49 | Good | 0.89 | Poor | 0.53 | Poor | 0.60 | Poor |
| UV activated wool | 0.31 | Good | 0.58 | Poor | 0.37 | Poor | 0.70 | Poor |
| wool | 0.24 | Good | 0.24 | Poor | 0.59 | Poor | 0.28 | Poor |
| Ꝋ water | stdevꝊwater | Ꝋ formamide | stdevꝊformamide | Ꝋ diiodomethane | stdevꝊdiiodomethane | |
|---|---|---|---|---|---|---|
| P1 | 114.14 | 3.02 | 116.14 | 4.21 | 114.14 | 8.48 |
| P2 | 112.59 | 7.62 | 118.64 | 2.57 | 118.12 | 6.84 |
| P3 | 110.21 | 6.95 | 112.57 | 8.47 | 119.12 | 4.33 |
| P4 | 110.64 | 4.95 | 117.93 | 4.75 | 118.11 | 3.96 |
| P5 | 114.10 | 4.84 | 112.32 | 3.78 | 113.18 | 5.49 |
| P6 | 117.35 | 2.73 | 125.00 | 3.39 | 119.58 | 4.23 |
| P7 | 119.75 | 5.07 | 106.14 | 3.42 | 115.05 | 5.01 |
| P8 | 109.92 | 6.81 | 125.36 | 3.78 | 108.41 | 4.87 |
| P9 | 102.02 | 6.80 | 107.96 | 4.20 | 110.59 | 4.21 |
| P10 | 109.27 | 9.85 | 109.27 | 3.27 | 108.11 | 3.00 |
| P11 | 118.26 | 6.35 | 116.79 | 3.13 | 107.90 | 3.19 |
| P12 | 109.62 | 4.04 | 109.62 | 2.97 | 112.59 | 6.05 |
| Untreated wool | 121.35 | 5.63 | 115.24 | 2.80 | 112.43 | 5.78 |
Publisher’s Note: MDPI stays neutral with regard to jurisdictional claims in published maps and institutional affiliations. |
© 2022 by the authors. Licensee MDPI, Basel, Switzerland. This article is an open access article distributed under the terms and conditions of the Creative Commons Attribution (CC BY) license (https://creativecommons.org/licenses/by/4.0/).
Share and Cite
Danila, A.; Costea, M.; Profire, L.; Rimbu, C.M.; Baican, M.; Lupascu, F.; Tatarusanu, S.-M.; Profire, B.-S.; Muresan, E.-I. A Sustainable Approach to a Cleaner Production of Antimicrobial and Biocompatible Protein Fibers. Polymers 2022, 14, 3194. https://doi.org/10.3390/polym14153194
Danila A, Costea M, Profire L, Rimbu CM, Baican M, Lupascu F, Tatarusanu S-M, Profire B-S, Muresan E-I. A Sustainable Approach to a Cleaner Production of Antimicrobial and Biocompatible Protein Fibers. Polymers. 2022; 14(15):3194. https://doi.org/10.3390/polym14153194
Chicago/Turabian StyleDanila, Angela, Mariana Costea, Lenuta Profire, Cristina Mihaela Rimbu, Mihaela Baican, Florentina Lupascu, Simona-Maria Tatarusanu, Bianca-Stefania Profire, and Emil-Ioan Muresan. 2022. "A Sustainable Approach to a Cleaner Production of Antimicrobial and Biocompatible Protein Fibers" Polymers 14, no. 15: 3194. https://doi.org/10.3390/polym14153194
APA StyleDanila, A., Costea, M., Profire, L., Rimbu, C. M., Baican, M., Lupascu, F., Tatarusanu, S.-M., Profire, B.-S., & Muresan, E.-I. (2022). A Sustainable Approach to a Cleaner Production of Antimicrobial and Biocompatible Protein Fibers. Polymers, 14(15), 3194. https://doi.org/10.3390/polym14153194










